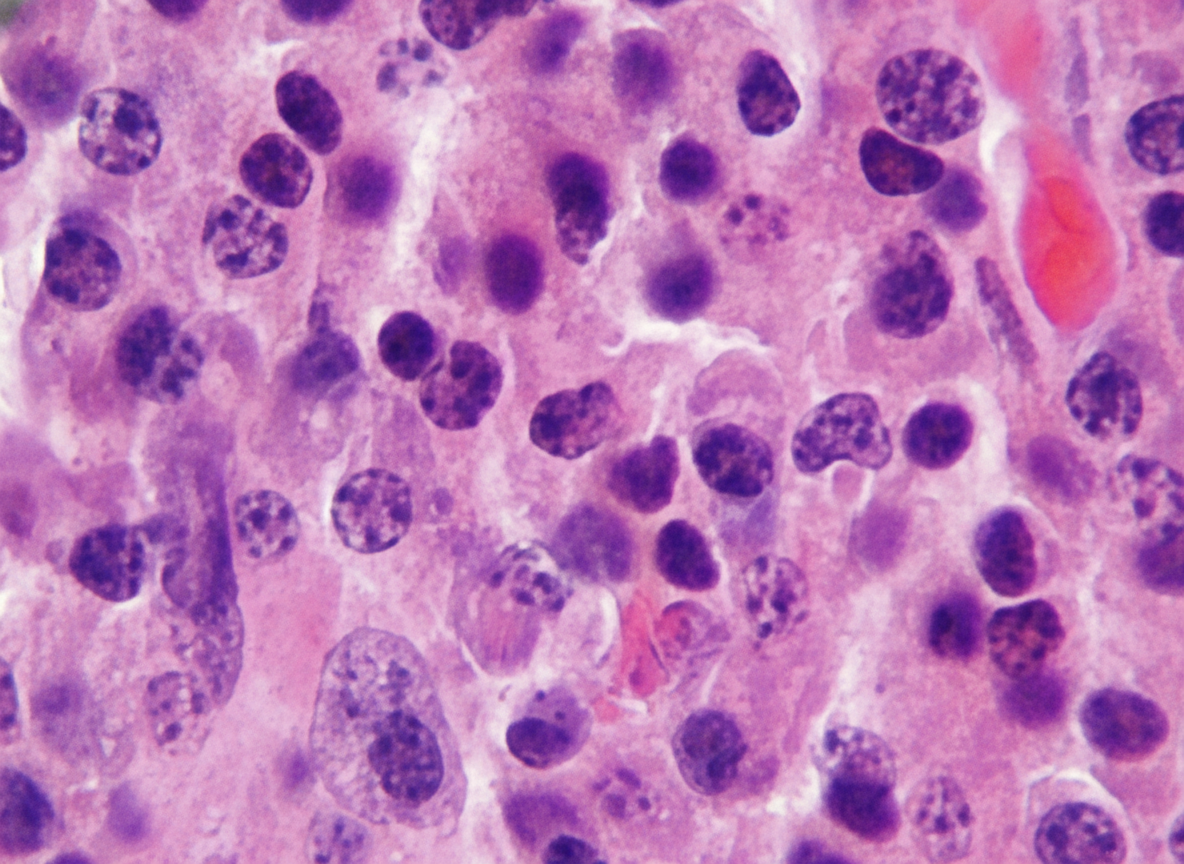
Image for question 12
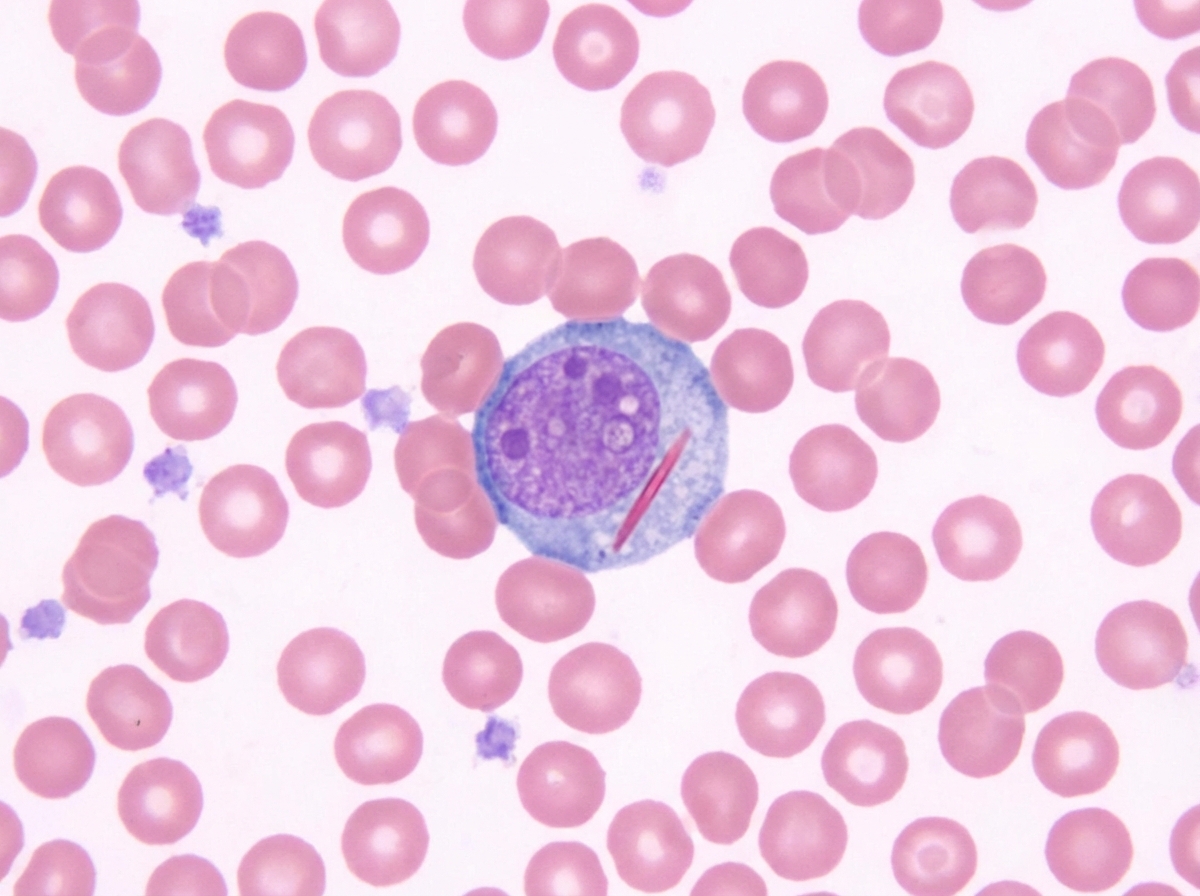
Image for question 14

The image shows electrophoresis report of multiple myeloma. The spike is present in:

A 7-year-old boy presents with swelling of cheek for 2 months. Biopsy from the lesions shows presence of:

Which instrument is shown below?

The following presentation can be seen in:

The following electron microscopy picture is a cytoplasmic feature seen in:

The image shows:
Name the anticoagulant used in the following method.

Name the inclusions shown in the blast.
This test is used as a screening tool for:

Name the test given.

Red blood cell disorders
Practice Questions
White blood cell disorders
Practice Questions
Platelet disorders
Practice Questions
Coagulation disorders
Practice Questions
Acute leukemias
Practice Questions
Chronic leukemias
Practice Questions
Myeloproliferative neoplasms
Practice Questions
Myelodysplastic syndromes
Practice Questions
Hodgkin lymphoma
Practice Questions
Non-Hodgkin lymphomas
Practice Questions
Plasma cell disorders
Practice Questions
Bone marrow failure syndromes
Practice Questions
Splenic pathology
Practice Questions
Get full access to all questions, explanations, and performance tracking.
Scan to download app
Enter your email to get your 85% OFF code and unlock the full USMLE question bank on the app.